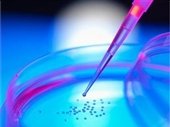

تولید سلولهای بنیادی از ادرار
شنبه ۰۸ دسامبر ۲۰۱۲ - ۱۸ آذر ۱۳۹۱
محققان اتریشی و چینی توانستهاند شیوه سادهتری را برای دستیابی به سلولهای بنیادی ایجاد کنند که جنجالهای موجود در مورد منابع این سلول مرجع را کاهش خواهد داد.
محققان اتریشی و چینی توانستهاند شیوه سادهتری را برای دستیابی به سلولهای بنیادی ایجاد کنند که جنجالهای موجود در مورد منابع این سلول مرجع را کاهش خواهد داد.
به گزارش ایسنا، جزئیات این شیوه مقرون به صرفه برای جداسازی سلولهای لازم و تبدیل آنها به سلول بنیادی در مجله نیچر منتشر شده است.
ظاهرا ادرار نه تنها حاوی ضایعات بلکه سلولهای کلیه است. این سلولها به هر طریق از لولههای کلیه بیرون آمده و وارد ادرار میشوند.
دانشمندان در این میان سلولهای اپیتلیال کلیوی را جداسازی کردهاند که پوسته بیرونی توبولها را که مسؤول انتقال مایعات هستند، پوشش میدهند.
تنها 30 میلیلیتر ادرار برای جمعآوری سلولهای کافی برای این فرآیند بسنده میکند. این سلولها طی فرآیندهای آزمایشگاهی از سایر موارد جدا شده و در یک سیستم کشت قرار میگیرند. سپس یک شیوه خاص که با اصلاح ژنتیکی کار میکند، منجر به تولید سلولهای بنیادی چندمنظوره میشود.
با قرار دادن چند ژن خاص در ژنوم این سلولها، یک تغییر اساسی در رفتار آنها بوجود میآید که باعث بازگشت آن به حالت سلول بنیادی میشود.
این دستاورد، اولین شیوه دستیابی به سلولهای بنیادی در آزمایشگاه نیست. علاوه بر آن، این شیوه نشان داده که منابع سلولهای بنیادی بسیار گسترده است و هنوز برخی از آنها شناخته نشدهاند.
alborzi - کرج - ایران
فکر کنم احمدی نژادو از این سلولها ساختن !
شنبه 18 آذر 1391 - 16:04
barfoburan - ژوهانسبورگ - آفریقای جنوبی
قدیمیا یه چیزی میدونستند ما بچه بودیم دستشون میبرید تو روستا میگفتند بش.. رو دستم ماهم می... سریع خون بند می اومد
شنبه 18 آذر 1391 - 16:12
Bond_James Bond - روتردام - هلند
قدر ادرارتون رو بدونید همینجوری هر جا که میرسید جیش نکنید.
شنبه 18 آذر 1391 - 21:49
artman - توکیو - ژاپن
به این می گن تقریبا از هیچی (البته نه هیچی هیچی) یه چیزی ساختن، کارشون و ایدشون جالبه
یکشنبه 19 آذر 1391 - 03:50
mobareze khamoosh - پردیس - ایران
میگن ما از گل درست شدیم!این شدیم !حالا یه سری آدم از ادرار درست کنن چه شود !!
یکشنبه 19 آذر 1391 - 21:21